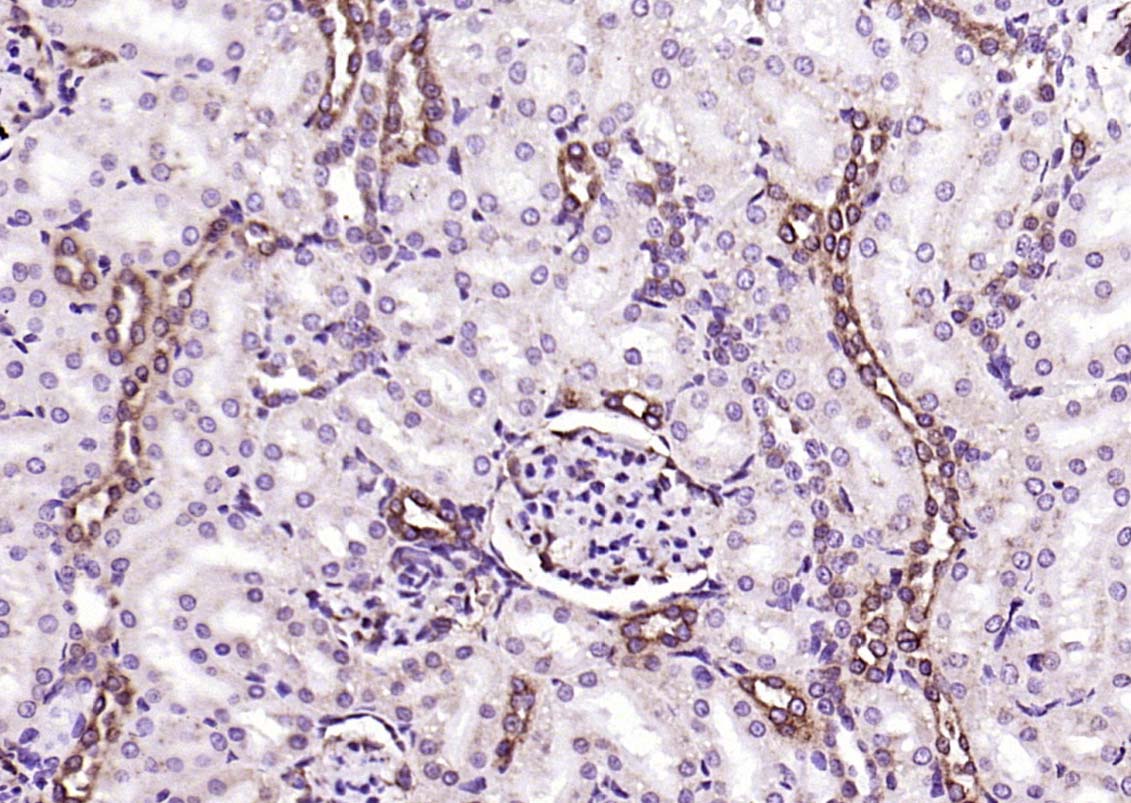
HA500444_3.jpg

PEPT1 Rabbit Polyclonal Antibody

cat.: HA500444
| Product Type: | Rabbit polyclonal IgG, primary antibodies |
|---|---|
| Species reactivity: | Human, Mouse, Rat |
| Applications: | WB, IHC-P, IF-Tissue |
| Clonality: | Polyclonal |
| Form: | Liquid |
| Storage condition: | Shipped at 4℃. Store at -20 ℃ for one year. Avoid repeated freeze/thaw cycles. |
| Storage buffer: | 0.01M TBS(pH7.4) with 1% BSA, 0.03% Proclin300 and 50% Glycerol. |
| Concentration: | 1ug/ul |
| Purification: | Protein A affinity purified. |
| Molecular weight: | 79 kDa |
| Isotype: | IgG |
| Immunogen: | KLH conjugated synthetic peptide derived from human PEPT1: 101-200/714(chk) <Cytoplasmic> |
| Subcellular location: | Membrane. |
| Recommended Dilutions:
WB IHC-P IF-tissue |
1:500-2000 1:100-500 1:100-500 |
| Uniprot #: | SwissProt: P46059 Human |
| Alternative names: | +peptide cotransporter HPECT1 HPEPT1 Human peptide transporter (HPEPT1) mRNA complete cds Intestinal H Intestinal H(+)/peptide cotransporter Oligopeptide transporter Oligopeptide transporter small intestine isoform PEPT1 Peptide transporter 1 S15A1_HUMAN Slc15a1 small intestine isoform Solute carrier family 15 (oligopeptide transporter) member 1 Solute carrier family 15 member 1 |
Images

|
Fig1:
Sample: Lane 1: Liver (Mouse) Lysate at 40 ug Lane 2: Liver (Rat) Lysate at 40 ug Lane 3: Panc-1 (Human) Cell Lysate at 30 ug Primary: Anti-SLC15A1 (bs-0689R) at 1/1000 dilution Secondary: IRDye800CW Goat Anti-Rabbit IgG at 1/20000 dilution Predicted band size: 80 kD Observed band size: 83 kD |

|
Fig2: Paraformaldehyde-fixed, paraffin embedded Mouse Kidney; Antigen retrieval by boiling in sodium citrate buffer (pH6.0) for 15 min; Antibody incubation with PEPT1 Polyclonal Antibody, Unconjugated (bs-0689R) at 1:200 overnight at 4°C, followed by conjugation to the SP Kit (Rabbit, SP-0023) and DAB (C-0010) staining. |
|
Fig3: Paraformaldehyde-fixed, paraffin embedded Rat Kidney; Antigen retrieval by boiling in sodium citrate buffer (pH6.0) for 15 min; Antibody incubation with PEPT1 Polyclonal Antibody, Unconjugated (bs-0689R) at 1:200 overnight at 4°C, followed by conjugation to the SP Kit (Rabbit, SP-0023) and DAB (C-0010) staining. |

|
Fig4: Paraformaldehyde-fixed, paraffin embedded Rat Small Intestine; Antigen retrieval by boiling in sodium citrate buffer (pH6.0) for 15 min; Antibody incubation with PEPT1 Polyclonal Antibody, Unconjugated (bs-0689R) at 1:200 overnight at 4°C, followed by conjugation to the SP Kit (Rabbit, SP-0023) and DAB (C-0010) staining. |

|
Fig5: Paraformaldehyde-fixed, paraffin embedded Mouse Small Intestine; Antigen retrieval by boiling in sodium citrate buffer (pH6.0) for 15 min; Antibody incubation with PEPT1 Polyclonal Antibody, Unconjugated (bs-0689R) at 1:200 overnight at 4°C, followed by conjugation to the SP Kit (Rabbit, SP-0023) and DAB (C-0010) staining. |

|
Fig6: Paraformaldehyde-fixed, paraffin embedded Human Gastric Cancer; Antigen retrieval by boiling in sodium citrate buffer (pH6.0) for 15 min; Antibody incubation with PEPT1 Polyclonal Antibody, Unconjugated (bs-0689R) at 1:200 overnight at 4°C, followed by conjugation to the SP Kit (Rabbit, SP-0023) and DAB (C-0010) staining. |

|
Fig7: Paraformaldehyde-fixed, paraffin embedded Human Colon Cancer; Antigen retrieval by boiling in sodium citrate buffer (pH6.0) for 15 min; Antibody incubation with PEPT1 Polyclonal Antibody, Unconjugated (bs-0689R) at 1:200 overnight at 4°C, followed by conjugation to the SP Kit (Rabbit, SP-0023) and DAB (C-0010) staining. |
Note: All products are “FOR RESEARCH USE ONLY AND ARE NOT INTENDED FOR DIAGNOSTIC OR THERAPEUTIC USE”.